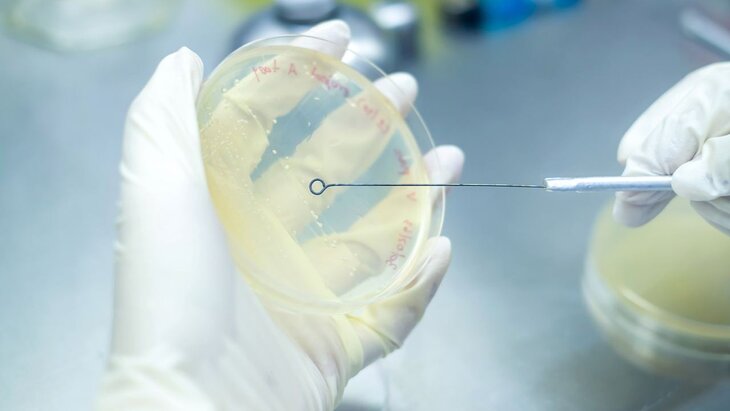

06 сентября 2023, 17:22
ОбществоВирус чумы свиней выявили в субпродуктах в одном из магазинов на Кубани
Фото: 123RF/pongchart
Вирус африканской чумы свиней выявили в субпродуктах, которые продавались в одном из магазинов города Тимашевска Краснодарского края. Об этом сообщает региональный Оперштаб.
"По решению владельца магазина эта продукция и вся находившаяся с ними в контакте была уничтожена", – говорится в сообщении.
Отмечается, что в помещении предприятия провели дезинфекцию. В настоящее время магазин закрыт.
В апреле этого года в России возобновили проверки производителей свинины из-за массовых случаев АЧС. На фоне ухудшения ситуации кабмином был разработан план по совершенствованию ветеринарной безопасности в РФ.
Новости регионов: вспышка африканской чумы свиней произошла на юге Красноярского края








Собянин: "Лужники" станут одной из лучших рекреационных зон Москвы



























